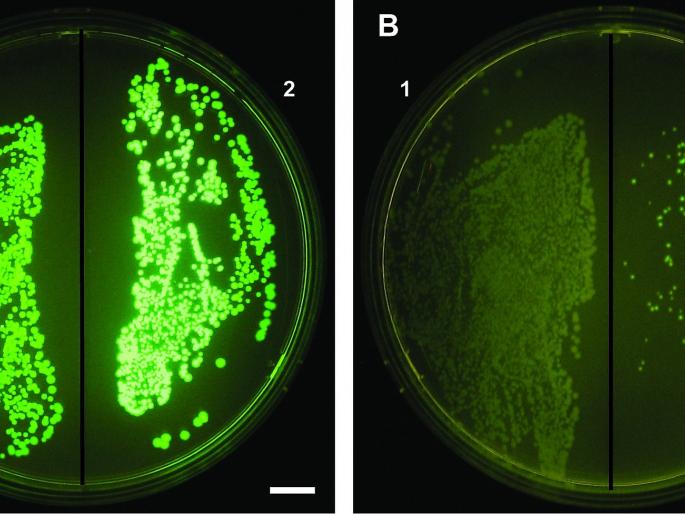
Fluorescent screening methods are now in use in Solapur for the diagnosis of myocardial infarction. | म्युकरमायकोसिसच्या निदानासाठी सोलापुरात आता फ्लोरोसेंट स्क्रिनिंग पध्दती वापरात Fluorescent screening methods are now in use in Solapur for the diagnosis of myocardial infarction. | म्युकरमायकोसिसच्या निदानासाठी सोलापुरात आता फ्लोरोसेंट स्क्रिनिंग पध्दती वापरात

म्युकरमायकोसिसच्या निदानासाठी सोलापुरात आता फ्लोरोसेंट स्क्रिनिंग पध्दती वापरात
By लोकमत न्यूज नेटवर्क | Updated: June 12, 2021 17:40 IST2021-06-12T17:40:08+5:302021-06-12T17:40:14+5:30
सिव्हिलमध्ये सुरुवात : ७२ रुग्ण घेताहेत उपचार
म्युकरमायकोसिसच्या निदानासाठी सोलापुरात आता फ्लोरोसेंट स्क्रिनिंग पध्दती वापरात
सोलापूर : सिव्हिल हॉस्पिटलमध्ये म्युकरमायकोसिसच्या निदानासाठी आता फ्लोरोसेंट स्क्रिनिंग ही नवी पद्धती वापरण्यात येत आहे. यामुळे बुरशी अत्यल्प प्रमाणात असली तरी ती ओळखता येणे शक्य होते, अशी माहिती अधिष्ठाता डॉ. संजीव ठाकूर यांनी दिली. याची सुरुवात शासकीय रुग्णालयात झाली असून, सध्या ७२ रुग्ण उपचार घेत असल्याचे त्यांनी सांगितले.
रुग्णाला म्युकरमायकोसिस आजार आहे की नाही याच्या निदानासाठी केओएच आणि कल्चर अशा दोन प्रकारच्या तपासण्या करण्यात येतात. या चाचणीमध्ये म्युकरचे प्रमाण कमी असल्यास लवकर निदान होत नाही. त्यामुळे फ्लोरोसेंट स्क्रिनिंग ही निदानाची पद्धती वापरण्यात येत आहे. या प्रकाराच्या निदानामध्ये म्युकर असलेली जागेमधील नमुना घेऊन त्यात विशिष्ट प्रकारचे केमिकल टाकले जाते. त्यानंतर मायक्रोस्कोपद्वारे पाहून निदान केले जाते. यामुळे म्युकरचे प्रमाण कमी असले तरी ते शोधणे सोपे जाते.
निदान लवकर झाल्यास त्यावर उपचार करणे लगेच सुरू करता येते. त्यामुळे ही निदान पद्धती वापरण्यात येत आहे. म्युकरमायकोसिसबद्दल जागृती होऊनदेखील रुग्ण उशिरा उपचारास येत असल्याचे रुग्णालय प्रशासनातर्फे सांगण्यात आले. रुग्ण वेळेवर उपाचारास आल्यास अधिक चांगल्या प्रकारे उपचार करता येणे शक्य असल्याचे प्रशासनातर्फे सांगण्यात आले.
६४ रुग्णांवर शस्त्रक्रिया
सिव्हिल हॉस्पिटलमध्ये सध्या म्युकरमायकोसीस आजाराचे दोन वॉर्ड करण्यात आले आहेत. नॉन कोविड म्युकरमायकोसिस हा बी ब्लॉकमध्ये तर कोविड म्युकरमायकोसीस हा ए ब्लॉकमध्ये सुरू आहे. दोन्ही मिळून ८० बेड या आजारासाठी आरक्षित करण्यात आले आहे. या आजाराच्या आतापर्यंत ६४ शस्त्रक्रिया करण्यात आल्या असून आणखी १५ शस्त्रक्रिया करण्यात येणार आहेत. सध्या सिव्हिलमध्ये ७२ रुग्ण उपचार घेत आहेत.